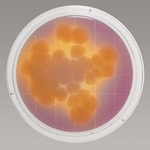
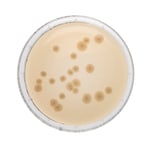
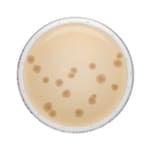

Search
- Home
- Shop All Products
- Contact And Settling Plates

Triple Wrap Sterile Pack w/VHP Indicator Tryptone Soya Agar
Experience next-level cleanroom confidence with Thermo Scientific™ Triple Wrap Sterile Pack Tryptone Soya Agar plates, complete with VHP Indicator.

Remel™ Isolator Wrap™ Sterile Sabauroud Dextrose Agar Contact Plate w/Lecithin, Polysorbate 80
Thermo Scientific™ Remel Isolator Wrap Sterile Sabauroud Dextrose Agar Contact Plate w/Lecithin, Polysorbate 80 is used for the cultivation of yeasts and fungi.
Remel™ Contact Plate Sterile D/E (Dey-Engley) Neutralizing Agar (Irradiated)
Thermo Scientific™ Remel Contact Plate Sterile D/E Neutralizing Agar (Irradiated) is used for the cultivation of microorganisms with neutralization of specific chemical disinfectants.

Remel™ Contact Plate Sterile Tryptic Soy Agar w/Lecithin, Polysorbate 80 (Irradiated)
Thermo Scientific™ Remel Contact Plate Sterile Tryptic Soy Agar with Lecithin, Polysorbate 80 (Irradiated) is for the cultivation of bacteria, yeast and fungi.

Sabouraud Dextrose Agar Irradiated (Triple Wrap) Plate
Experience next-level cleanroom confidence with Thermo Scientific™ Oxoid™ Sabouraud Dextrose Agar Plate. The Sabouraud Dextrose Agar supports the growth of yeasts, fungi and molds.
Tryptone Soya Agar Irradiated Triple Wrap Contact Plate
Perform effortless surface sampling in the most regulated environments using Thermo Scientific™ Oxoid™ Tryptone Soya Agar Irradiated Triple Wrap Contact Plate. Tryptone Soya Agar is a general purpose medium containing two peptones.

Tryptone Soya Agar Contact Plate
Grow a wide variety of microorganisms with Thermo Scientific™ Oxoid™ Tryptone Soya Agar Contact Plate. The general purpose medium, containing two peptones, supports the growth of wide variety of organisms. It is suitable for the cultivation of both aerobes and anaerobes.

Triple Wrap Sterile Pack w/VHP Indicator Tryptone Soya Agar w/Lecithin, Polysorbate 80, Sodium Thiosulphate, L-Histidine
Experience next-level cleanroom confidence with Thermo Scientific™ Triple Wrap Sterile Pack Tryptone Soya Agar plates, complete with VHP indicator, Lecithin, Polysorbate 80, Sodium Thiosulphate and L-Histidine.
Tryptone Soya Agar + TWEEN / lecithin55 Contact Plate
Grow a wide variety of microorganisms with Thermo Scientific™ Oxoid™ Tryptone Soya Agar with TWEEN/Lecithin 55 Irradiated Triple Wrap Contact Plate. The general purpose medium, containing two peptones, supports the growth of wide variety of organisms.

Tryptone Soya Agar Irradiated (Triple Wrap) Plate
Experience next-level cleanroom confidence with Thermo Scientific™ Oxoid™ Tryptone Soya Agar Irradiated Plate. The Tryptone Soya Agar supports the growth of wide variety of organisms.

Remel™ Contact Plate Sterile Sabouraud Dextrose Agar w/Lecithin, Polysorbate 80 (pH 5.6) (Irradiated)
Thermo Scientific™ Remel Contact Plate Sterile Sabouraud Dextrose Agar with Lecithin, Polysorbate 80 (pH 5.6) (Irradiated) is used for the cultivation of yeast and fungi.
